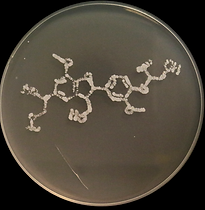

Dec. 10, 2025
We are honored to be recognized as a 2026 Rising Star in Biological, Medicinal, and Pharmaceutical Chemistry by ACS Bio & Med Chem Au!
December 6, 2024
Cancerworld reported on our findings that gut bacteria a key piece of the puzzle in therapy with tamoxifen for people with breast cancer. Check out the press release here!
August 21, 2024
Delighted to be awarded an NIH R01 from NINDS to support our research on chemical factors that control the gut microbiome's role in Parkinson's disease.
Jun. 23, 2022
Check out our Article in J. Appl. Microbiol. on an a way that gut bacteria can synthesize dopamine.

Mar. 23, 2021
Congratulations to graduate student Zane Long for being awarded an Honorable Mention for his application to the NSF Graduate Research Fellowship Program!

June 16, 2020
Bess Lab awarded UC Irvine Hellman Fellowship!

Sept. 9, 2025
PhD candidate Julia Balsamo wins the prize for best poster at the University of California Chemical Symposium held at Lake Arrowhead. Congrats,
Julia!
November 25, 2024
Our findings that gut bacteria control the blood concentration of anti-breast cancer drug tamoxifen is published in mBio. Check out the press release and Commentary!
Oct. 7, 2022
Thanks to support from the ACS TheoryLab Collaborative Grant, the Bess and Jang Labs are mapping the gut microbiome's role in fighting breast cancer.
Jun. 8, 2022
Check out our pre-print on bioRxiv showing how gut bacteria convert dopamine, iron, and α-synuclein into a toxic trio that causes α-synuclein aggregation and neurodegeneration

Jan. 5, 2021
Congratulations to 3rd-year graduate student Barry Rich for receiving the prestigious ARCS Scholar Award.

Jan. 10, 2020
Professor Bess named a Scialog fellow by Research Corp.
Sept. 5, 2025
We developed a snappy LC-MS/MS method to simultaneously quantify in human fecal samples 17 molecules derived from dietary plants. Read more at bioRxiv!

November 10, 2024
CBS News Radio highlighted our research about Parkinson's disease. Listen here!
July 3, 2024
We're using electro-chemistry to enable rapid screening of inhibitors of α-synuclein aggregation. Read all about it in ACS Chemical Neuroscience.
Aug. 24, 2021
Check out our Commentary in mSystems about how C. elegans can be used to dissect the gut–grain axis.

Oct. 1, 2020
Honored to be supported by the UC Cancer Research Coordinating Committee for our research on the gut microbiome's role in breast cancer therapy.

Oct. 10, 2019
Honored to be supported by the American Cancer Society and UCI for our work on estrogen and the gut microbiome.
Aug. 30, 2025
We found that inhibiting dopamine production in intestinal cells using an existing medicine inhibits Parkinsonian α-synuclein aggregation. Read more at bioRxiv!
November 6, 2024
Live Science reports highlights our research in "E. coli in the gut may fuel a 'chain reaction' leading to Parkinson's, early study suggests." Read the article here.
Mar. 22, 2024
Our contribution to the first molecular-level mechanism connecting gut bacteria to intestinal α-synuclein aggregation is published in ACS Chemical Biology.

May. 28, 2021
Congratulations to Kylie Uyeda and Zane Long, the newest PhD candidates in the Bess Lab!
July 31, 2020
Delighted to be supported by the Global Probiotics Council to study the chemical reactions that gut bacteria perform when they degrade fiber.
Jan. 2, 2025
Futurity's article on our research describing how Parkinson's Disease may originate in the gut was one of the Top 10 Stories of the Year!
October 25, 2024
Our discoveries about Parkinson's disease and the gut microbiome were featured on Futurity. Check out the article here.
Dec. 29, 2023
Thrilled to be awarded an NSF CAREER grant to support our research on lignin digestion by bacteria.

Mar. 23, 2021
Congratulations to graduate student Kylie Uyeda for being awarded an Honorable Mention for her application to the NSF Graduate Research Fellowship Program!

July 17, 2020
Bess Lab celebrates its first student advancing to PhD candidacy! Congratulations, Barry!